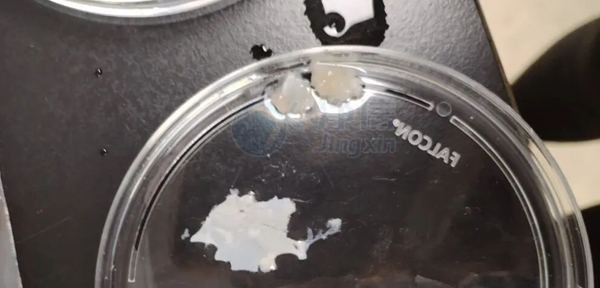

一、骨骼研究的細胞關卡
骨骼肌作為機體代謝與運動的關鍵組織,其細胞異質性研究近年來成為前沿熱點。無論是肌肉再生機制探索、衰老研究,還是肌少癥等疾病模型的構建,獲取高質量的單細胞懸液都是下游單細胞RNA測序、流式分析等技術的決定性一步。
傳統的小鼠骨骼肌解離長期面臨嚴峻挑戰:手工研磨與酶消化相結合的方法不僅耗時費力(常需3-4小時),且細胞得率與活性波動大,這些痛點直接制約了實驗的重復性與數據質量。
二、儀器優勢:程序化與溫和解離的革命
凈信單細胞懸液制備儀的核心突破在于,它將原本分散、依賴人工經驗的多步操作整合進一個封閉、自動化的系統。其優勢顯著:
1.程序化消解:精準控溫以及轉速可控,避免因手工操作不一致導致的過度消化或消化不足。
2.保護細胞活性:溫和的磁珠運動替代暴力研磨,配合實時溫控,將細胞從應激損傷中“解放”出來,保障高活性。
三、實驗關鍵步驟
1.樣本前處理
快速取得骨骼肌,置于緩沖液中,去除明顯脂肪與筋膜,將組織轉移到消化管中,使用眼科剪剪碎,加入適量消化酶(采用酶離者的骨骼肌組織消化試劑盒)。
2.儀器參數設置
在儀器觸控面板設定消化程序(37℃,選擇合適的消化程序),點擊啟動,儀器開始運行。
消化過程中可以打開蓋子(運行暫停)觀察消化狀態。

3.樣本處理過程
解離完成后可以取出消化管,使用40微米的濾網過濾,隨后加入適量的終止液終止消化。根據情況可搭配去碎片劑去除細胞碎片。
4.收樣與質檢
收樣與質檢,離心洗滌后,使用臺盼藍染色或AOPI染料,使用細胞計數器評估細胞活性與數量。所得懸液可直接用于10x Genomics單細胞建庫或流式分選。
5.實驗結果
本次制備的骨骼肌細胞活率達到96.43%。

單細胞懸液制備儀的引入,將研究人員從繁瑣、高變異性的手工勞動中解放出來,使得高通量、高重復性的骨骼肌單細胞研究成為可能。這不僅提升了數據產出質量,更縮短了實驗周期,讓科研人員能將精力更多地集中于科學問題本身。
該技術的穩定應用,正助力我們更清晰地解析骨骼肌中干細胞、肌纖維、免疫細胞等群體間的互作網絡,為理解肌肉生理與病理打開一扇更精細的窗口。未來,隨著程序的進一步優化,它有望拓展至更多纖維化程度高、難解離的組織類型,持續推動組織生物學研究進入單細胞新時代。

